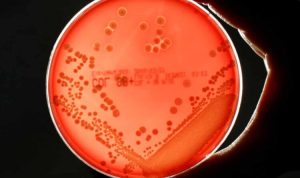

Salah satu hal penting yang harus diperhatikan dalam produk pangan adalah label masa kedaluwarsa. Tak sedikit masyarakat yang beranggapan bahwa produk makanan harus diturunkan dari rak toko tiga bulan sebelum tanggal kedaluwarsa. Benarkah demikian?
Merujuk Pasal 3 ayat (2) Peraturan Pemerintah (PP) Nomor 69 Tahun 1999 tentang Label dan Iklan Pangan, disebutkan bahwa label pangan setidaknya harus memuat keterangan mengenai nama produk, daftar bahan yang digunakan, berat bersih atau isi bersih, nama dan alamat pihak yang memproduksi atau mengimpor pangan ke Indonesia, tanggal kedaluwarsa, dan nomor registrasi.
Selain itu, Pasal 2 dalam aturan yang sama menyebutkan bahwa pencantuman label harus dilakukan sedemikian rupa agar tidak mudah lepas dari kemasan, tidak luntur atau rusak, serta diletakkan pada bagian kemasan yang mudah dilihat dan dibaca.
Penulisan batas kedaluwarsa pada label pangan umumnya dilakukan dengan mencantumkan bulan dan tahun, kecuali bila menggunakan format empat digit angka. Sesuai Lampiran 3 Peraturan Kepala Badan POM RI tentang Pendaftaran Pangan Olahan Tahun 2011, ukuran minimal huruf untuk penulisan tanggal kedaluwarsa pada label adalah 1 mm (setara dengan font Arial 6 point).
Menanggapi persepsi masyarakat mengenai penurunan produk dari rak pajangan tiga bulan sebelum kedaluwarsa, Dra. Adilah Pababbari, Apt, MM menjelaskan bahwa yang dilakukan bukanlah menurunkan produk, melainkan memisahkannya untuk keperluan sistem distribusi yang mengikuti prinsip First In First Out (FIFO).
“Yang dilakukan adalah memisahkan agar sistem distribusi jelas sesuai First In First Out,” ujarnya, dikutip dari laman resmi BPOM.
Ia menegaskan, produk yang masih dalam kondisi baik namun telah melewati masa kedaluwarsa tidak dijamin keamanannya jika tetap dikonsumsi. Sebaliknya, produk yang sudah mengalami kerusakan, meski tanggal kedaluwarsanya masih jauh, juga tidak disarankan untuk dikonsumsi.***